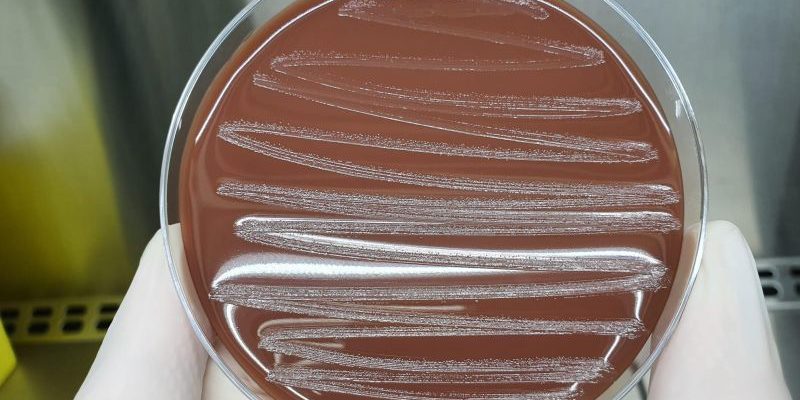

La Glaesserella parasuis, anteriormente conocida como Haemophilus parasuis, es una bacteria comensal habitual de las vías respiratorias de los cerdos.
En las condiciones adecuadas, ocasiona brotes agudos de enfermedad, ataca las superficies serosas que recubren las articulaciones, intestino, pulmones, corazón y cerebro, causando neumonía, infección del pericardio, peritonitis y pleuritis.
Se puede observar en granjas porcinas de todo el mundo y normalmente está relacionada con eventos estresantes como el destete demasiado pronto o el movimiento y la mezcla de animales. Su aparición también puede verse favorecida por infecciones con otros #patógenos.
Gracias al diagnóstico personalizado, desde Zenit podemos detectar la Glaesserella parasuis con rapidez para así empezar el tratamiento más adecuado a la granja.